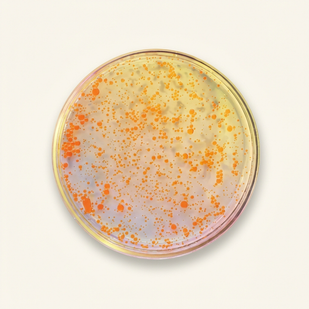
Panthenol (Vitamine B5)

🚚 Livraison GRATUITE — Votre peau apaisée dans 6 à 7 jours






















Rosyra Sérum Anti-Rougeurs
Traite les problèmes de rosacée suivants :
(Sélectionnez un symptôme pour voir comment il est traité)
 Rougeurs
Rougeurs
 Bouffées de chaleur
Bouffées de chaleur
 Pustules
Pustules
 Vaisseaux apparents
Vaisseaux apparents
Ingrédients Naturels
Des actifs naturels puissants pour apaiser les rougeurs et retrouver une peau uniforme

Niacinamide
Réduit les rougeurs et renforce la barrière cutanée pour une peau plus résistante et apaisée.
Panthenol (Vitamine B5)
Réduit l'inflammation et les rougeurs, améliore le grain de peau et unifie le teint.

Acide Hyaluronique
Hydrate intensément sans alourdir la peau et réduit les sensations de tiraillement.

Extraits Botaniques Apaisants
Apaise les sensations de brûlure et atténue visiblement les rougeurs du visage.
Elles l'ont adopté.
Découvrez leurs résultats.



Ils parlent de nous :


Résultats impressionnants
Mon dermatologue a remarqué que mes poussées de rosacée étaient plus douces et que ma peau était globalement plus lisse.
Facile à appliquer
Je l’utilise matin et soir depuis quelques semaines. La texture est légère, pénètre rapidement et ne laisse pas de film collant. Ma peau paraît plus apaisée et les rougeurs sont moins visibles. Très agréable à intégrer dans ma routine.
Le meilleur investissement pour ma peau
Je ne regrette pas du tout mon achat. Ma peau est plus apaisée, plus uniforme et les rougeurs sont nettement moins visibles. Je me sens enfin plus en confiance sans maquillage.
Service client au top !
Réponse rapide, équipe à l’écoute et très professionnelle. Rien à redire.
Nos Experts
Nos dermatologues certifiés

Dr. Camille Beaumont
Dermatologue spécialisée en rosacée depuis plus de 15 ans.

Dr. Martin Vasseur
Expert en dermatologie des peaux sensibles et réactives.

Dr. Thomas Aubry
Spécialiste en éclat du teint et traitement des taches solaires et du mélasma.
Questions fréquentes
Les traitements topiques et le laser peuvent tous deux apaiser la rosacée, réduire les rougeurs et uniformiser le teint. Cependant, le laser nécessite un temps de récupération plus long, coûte plus cher et comporte davantage de risques, tandis que les soins topiques sont plus doux et faciles à utiliser chez soi.
Les traitements de la rosacée utilisent généralement des ingrédients doux et apaisants qui réduisent les rougeurs et l'inflammation, comme la niacinamide, le panthenol et l'acide hyaluronique. On les retrouve dans des formules topiques comme le sérum anti-rougeurs Rosyra. Il est également essentiel d'appliquer un SPF 30 minéral chaque jour, car le soleil peut déclencher des poussées et aggraver les rougeurs.
Pour apaiser la rosacée et réduire les rougeurs, le sérum anti-rougeurs Rosyra est une excellente option. Il est formulé avec des actifs doux qui ciblent l'inflammation, apaisent les irritations et améliorent l'uniformité du teint. Pour de meilleurs résultats, suivez les instructions d'application régulièrement et associez-le à une protection solaire de qualité.
Pour apaiser la rosacée et réduire les rougeurs, le sérum anti-rougeurs Rosyra est une excellente option. Il est formulé avec des actifs doux qui ciblent l'inflammation, apaisent les irritations et améliorent l'uniformité du teint. Pour de meilleurs résultats, suivez les instructions d'application régulièrement et associez-le à une protection solaire de qualité.
Pour apaiser les rougeurs et uniformiser le teint, le sérum anti-rougeurs Rosyra offre une formule douce et ciblée, conçue pour les peaux sensibles sujettes à la rosacée. Il aide à réduire les poussées visibles et favorise un teint plus calme et équilibré. Pour de meilleurs résultats, suivez les instructions d'application et protégez votre peau du soleil.
- Après le nettoyage, appliquez quelques gouttes sur les zones concernées et massez délicatement.
- Peut être utilisé en soin localisé, sur l'ensemble du visage, ou selon les recommandations de votre dermatologue.
- Appliquez ensuite un soin hydratant doux pour apaiser votre peau.
- Portez toujours une protection solaire minérale SPF 30 minimum, car les peaux rosacées sont plus sensibles au soleil.
- Vous pouvez observer une amélioration des rougeurs en 30 minutes à 1 heure, avec un effet maximal en environ 6 heures.
- Un flacon correspond à environ 2 mois d'utilisation.
Oui ! Vous pouvez utiliser le sérum anti-rougeurs Rosyra avec votre routine de soins habituelle. Pour de meilleurs résultats, appliquez-le après le nettoyage et avant votre soin hydratant. Laissez bien chaque produit pénétrer avant d'appliquer le suivant — cela aide à apaiser les rougeurs et à uniformiser le teint.
Notre sérum est formulé avec des ingrédients doux et sûrs, adaptés aux peaux les plus sensibles. Il est sans parabènes et sans sulfates.
Oui ! Il est parfaitement adapté aux peaux rosacées et sensibles. Notre formule approuvée par des dermatologues est douce mais efficace, aidant à apaiser les rougeurs tout en convenant à tous les types de peau.















